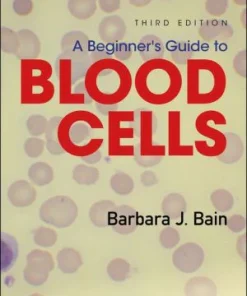
A Beginner's Guide to Blood Cells 3rd Edition

Shop
Showing 388–396 of 26071 results
-
Sale!

9/11 and the Visual Culture of Disaster
Original price was: د.إ124.00.د.إ75.00Current price is: د.إ75.00. Add to cart Quick View Compare -
Sale!

90 Days to Success Marketing and Advertising Your Small Business
Original price was: د.إ150.00.د.إ75.00Current price is: د.إ75.00. Add to cart Quick View Compare -
Sale!

911 Responding for Life Case Studies in Emergency Care
Original price was: د.إ160.00.د.إ75.00Current price is: د.إ75.00. Add to cart Quick View Compare -
Sale!

A Back and Forth between Tourism and Health: From Medical Tourism to Global Health
Original price was: د.إ605.00.د.إ175.00Current price is: د.إ175.00. Add to cart Quick View Compare -

A Bailey & Love Revision Guide MCQs and EMQs in Surgery 2nd Edition
Call for Price Price Ask Via WhatsApp Quick View Compare -
Sale!

A Basic Course in Real Analysis
Original price was: د.إ375.00.د.إ200.00Current price is: د.إ200.00. Add to cart Quick View Compare -
Sale!

A Basic Guide to International Business Law
Original price was: د.إ232.00.د.إ100.00Current price is: د.إ100.00. Add to cart Quick View Compare -
Sale!

A Basic Theory of Everything
Original price was: د.إ1,058.00.د.إ250.00Current price is: د.إ250.00. Add to cart Quick View Compare